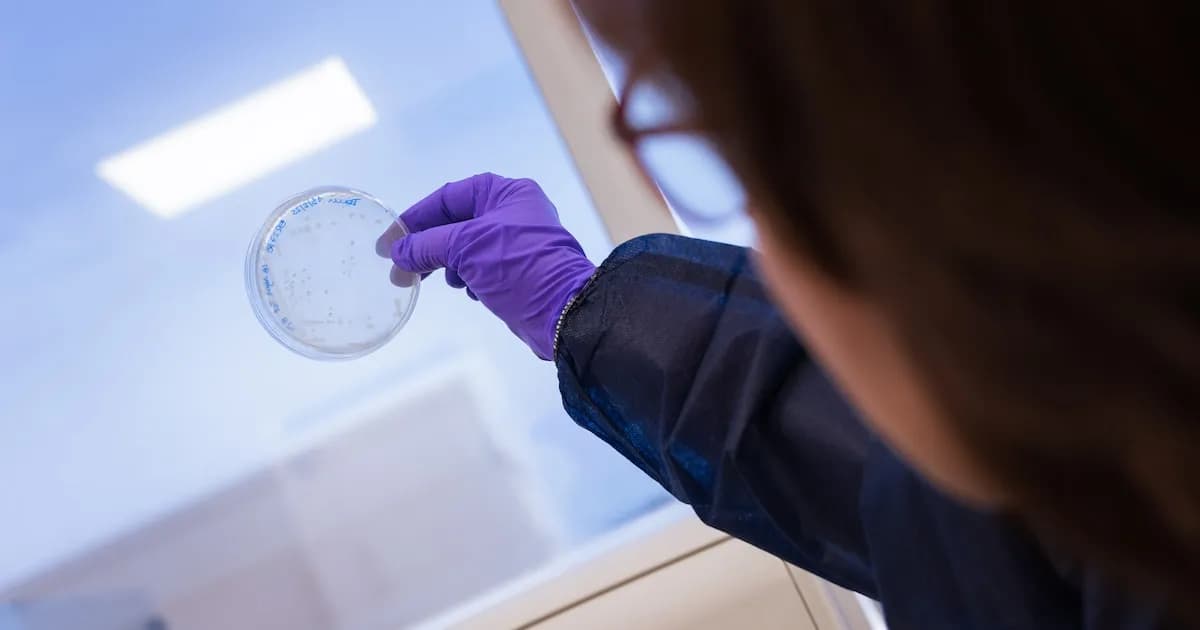
Revelan una bacteria que podría transformar el tratamiento de la enfermedad de Crohn

Un reciente descubrimiento ha identificado una bacteria de la microbiota intestinal que podría revolucionar el tratamiento de la enfermedad de Crohn. Investigadores de la Universidad de la Sorbona en Francia han señalado que la Faecalibacterium prausnitzii podría cambiar la manera en que se abordan las enfermedades inflamatorias crónicas del intestino.
El estudio, que ha sido publicado en la revista Gastroenterology, destaca la notable reducción de esta bacteria en individuos diagnosticados con enfermedad de Crohn. Esta condición se caracteriza por un desequilibrio en la microbiota y una inflamación intestinal persistente y dolorosa. Investigaciones recientes han demostrado que la Faecalibacterium prausnitzii juega un papel fundamental en la salud intestinal, ya que su presencia está asociada a un estado saludable, mientras que su ausencia se vincula con diversas enfermedades inflamatorias y algunos tipos de cáncer.
La enfermedad de Crohn es una afección crónica que provoca inflamación en el tracto digestivo y puede afectar cualquier parte del mismo, siendo más prevalente en el intestino delgado y el colon. Sus síntomas incluyen diarrea, dolor abdominal, fatiga extrema, sangrado rectal y pérdida de peso. Aunque no existe una cura definitiva, los tratamientos médicos pueden ayudar a controlar la inflamación y aliviar los síntomas. Los científicos han observado que la Faecalibacterium prausnitzii puede aumentar la producción de interleucina-10 (IL-10), una citocina con propiedades antiinflamatorias, lo que abre nuevas posibilidades para el manejo de esta compleja enfermedad.